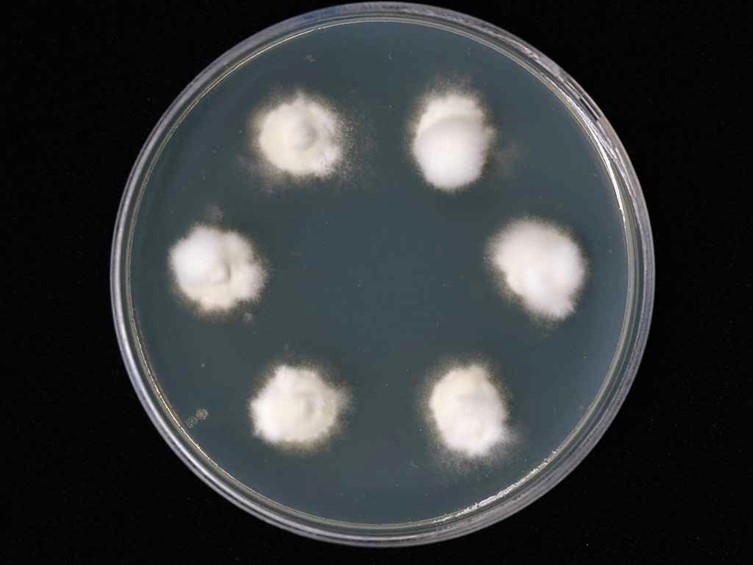

Holotype:
USA, Washington D.C., on Plusia brassicae, collection date unknown, R. Thaxter.
Habitat:
Buried in the ground.
Host:
Lepidoptera larvae.
Description:
 Host covered by a thin white felt of hyphae, pulverulent, from which numerous compact conidiophores arise, producing a mass of greenish white to pale green
Host covered by a thin white felt of hyphae, pulverulent, from which numerous compact conidiophores arise, producing a mass of greenish white to pale green  conidia. Hyphae septate, smooth-walled, hyaline, 1.5-3 µm wide, occasionally branched. Conidiophores erect, smooth-walled 2.5-4 µm wide, forming dense clusters of short metulae beneath the septa, solitary or in whorls of 2-6, each bearing 2-6 compacted
conidia. Hyphae septate, smooth-walled, hyaline, 1.5-3 µm wide, occasionally branched. Conidiophores erect, smooth-walled 2.5-4 µm wide, forming dense clusters of short metulae beneath the septa, solitary or in whorls of 2-6, each bearing 2-6 compacted  phialides around the stalk, or rising directly from the conidiophores, occasionally with short branches from the conidiophores and forming conidiogenous structures. Phialides subglobose to short cylindrical or ampulliform with a globose base, 2.5-5 × 2.5-4 µm with very short necks, smooth-walled, hyaline. Conidia ellipsoidal, 2.5-5 × 2-3 µm.
phialides around the stalk, or rising directly from the conidiophores, occasionally with short branches from the conidiophores and forming conidiogenous structures. Phialides subglobose to short cylindrical or ampulliform with a globose base, 2.5-5 × 2.5-4 µm with very short necks, smooth-walled, hyaline. Conidia ellipsoidal, 2.5-5 × 2-3 µm.
Culture characteristics:
Colonies on PDA are relatively fast-growing, attaining a diam of 10 mm in 7 d at 25˚C.
Colonies on PDA are relatively fast-growing, attaining a diam of 10 mm in 7 d at 25˚C.
Reference:
Kepler RM, Humber RA, Bischoff JF, et al. (2014). Clarification of generic and species boundaries for Metarhizium and related fungi through multigene phylogenetics. Mycologia 106: 811–829.
DOI: http://doi.org/10.3852/13-319Mongkolsamrit S, Khonsanit A, Thanakitpipattana D, et al. (2020). Revisiting Metarhizium and the description of new species from Thailand. Studies in Mycology 95: 171–251.
DOI: https://doi.org/10.1016/j.simyco.2020.04.001Species |
Strain |
Compound |
Pubchem CID |
Biological activity |
Reference |
|---|
|
Strain |
ITS | LSU | RPB1 | RPB2 | SSU | TEF1 |
|---|---|---|---|---|---|---|
| AF 368501 | AF368501 | - | - | - | - | - |
| CBS 806.71 | AY624205 | - | EF468893 | EF468937 | AY526491 | EF468787 |
| NBRC 8560 | HQ165729 | - | - | HQ165667 | HQ165688 |